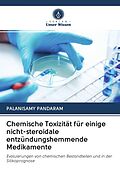

Willkommen. Schön, sind Sie da!
0

Chemische Toxizität für einige nicht-steroidale entzündungshemmende Medikamente
Rabatt
Beschreibung
Die nicht-steroidalen Antirheumatika (NSAR) gehören zu den erfolgreichsten Medikamenten der Welt und werden aufgrund ihrer entzündungshemmenden, schmerzstillenden und fiebersenkenden Wirkung von einer großen Zahl von Patienten verwendet. Diese NSAR sind jedoch...Format auswählen
- Kartonierter EinbandCHF 28.70
Kartonierter Einband
CHF 31.90
CHF28.70-10%Sie sparen CHF 3.20
CHF28.70
Print on Demand - Exemplar wird für Sie besorgt.
Kostenlose Lieferung
